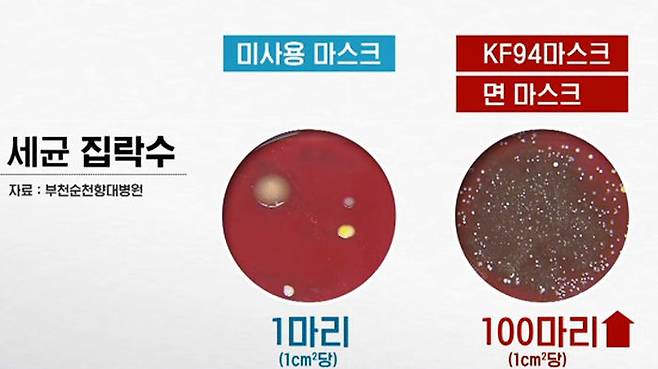

습한 여름날, 마스크 하루 쓴 뒤 세균 검사해 보니..
<앵커>
이제는 마스크가 필수품이 된 지 오랜데요, 새 걸 꺼내면 얼마나 착용하시나요? 온도도 습도도 높은 요즘 하루 정도 쓴 마스크 안쪽에서 세균이 얼마나 자라는지 마스크 종류별로 실험한 결과를 전해드립니다.
송인호 기자입니다.
<기자>
30도 안팎 무더위 속에서 야외 공원의 그늘을 찾은 시민들, 대부분 마스크를 쓰고 있습니다.
[유정수/임신부 : 좀 고위험군이다 보니까 그래도 KF94가 조금 더 안전하다고 느껴서 사람 많은 장소 같은 곳에서는 쓰고 있어요.]
[최은선/주부 : 여름이 돼서 덥기도 하고 숨이 좀 차기도 해서 덴탈 마스크로 바꾸었어요.]
야외에서 마스크를 쓰고 걸을 때 마스크 안쪽의 온도와 습도는 어떻게 변할까?
KF94와 비말 차단, 면, 덴탈 등 4종류의 마스크로 실험해봤습니다.
각각의 마스크를 쓰고 1km를 걷게 한 뒤 100m 단위로 마스크 안쪽 습도를 측정한 결과 4종류 모두 80%를 웃돌았습니다.
대기 중 습도의 2배에 가까운 수준입니다.
마스크 안쪽의 온도 역시 피부 표면보다 최고 2도 이상 높았습니다.
불편감은 필터 기능이 뛰어난 KF94 마스크를 착용할 때 가장 컸습니다.
[한성규/KF94마스크 착용 피실험자 : 지금 땀이 송글송글 맺히고 있어요. 덥네요. KF94는 진짜 답답해요.]
문제는 마스크 안쪽의 습도와 온도가 높다 보니 세균이 쉽게 자랄 수 있다는 점입니다.
하루 정도 사용한 4종류의 마스크로 세균 배양 실험을 한 결과 모든 마스크에서 피부와 입안에서 서식하는 균들이 검출됐습니다.
특히 면 마스크와 KF94 마스크에서 가장 많은 세균이 나왔고 일부 마스크에서는 슈퍼박테리아라 불리는 항생제 내성균도 검출됐습니다.

[신희봉/순천향대 부천병원 진단검사의학과 교수 : KF94마스크의 특성상 다른 마스크에 비해 상대적으로 통기성이 떨어져 균이 더 많이 검출되었을 가능성이 하나 있고요.]
전문가들은 무더운 여름철 야외에서는 가급적 통기성이 좋은 마스크를 쓰고 마스크 종류와 상관없이 자주 갈아줘야 한다고 말합니다.
[김호중/순천향대 부천병원 응급의학과 교수 : 면역이 떨어진 분들한테는 포도상구균, 연쇄상구균 같은 경우가 굉장히 치명적 결과를 초래하기 때문에, 내가 쓴 마스크는 절대 다른 사람한테 쓰게 해서는 안 되고, 가능한 하루 정도 넘어가는 마스크 사용은 최대한 자제하는 게 좋습니다.]
차제에 마스크 착용과 관련한 방역당국의 구체적 지침 마련도 필요해 보입니다.
(영상취재 : 장운석·박현철, 영상편집 : 이소영, VJ : 신소영, 촬영협조 : 동아오츠카)

송인호 기자songster@sbs.co.kr
Copyright © Copyright ⓒ SBS. All rights reserved. 무단 전재, 재배포 및 AI학습 이용 금지
- 구급차 막은 택시기사 구속..유가족에 남긴 한마디
- [CCTV 영상] "5분 만에 2m 훌쩍" 지하차도 침수 순간
- [제보] "미쳤다" 말 잃은 부산..'홍수경보' 문자 혼란
- "은주야! 안돼!" 어느 장애 가정 덮친 '돌봄 지옥'
- [영상] 만취해 무법 질주, 택시 운전석 그대로 '쾅'
- '괴물 미사일' 성공 축하..문 대통령이 언급한 이유
- 故 구하라 일기장 공개 "나 데리고 바람 피우더니.."
- "박원순 실종 당일 통화 내용?" 묻자, 남인순의 대답
- "살려고 발버둥" 죽다 살아난 코로나 환자, 뼈있는 한마디
- "나은 학폭글 거짓말입니다"..자필 사과문 등장